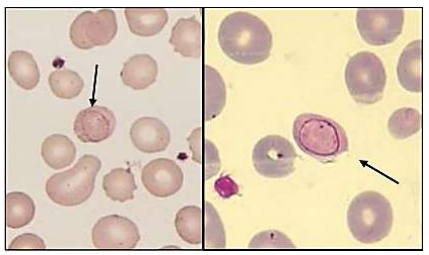
Enunciado 3265368-1

Foram encontradas 480 questões.
Menino, 18 meses, albino, em atual investigação de infecções bacterianas recorrentes, realizou o seguinte exame:

Qual é o tipo de alteração encontrada?

Qual é o tipo de alteração encontrada?
Provas
Questão presente nas seguintes provas
Os métodos enzimáticos colorimétricos são os mais empregados atualmente em laboratórios clínicos para a determinação do colesterol total; do HDL-c; e, dos triglicerídeos. Para o LDL-c há duas opções: o cálculo pela fórmula de
Friedewald
ou a dosagem direta. Em relação ao cálculo pela fórmula de
Friedewald
, assinale, a seguir, a condição considerada uma
exigência para que o resultado seja confiável.
Provas
Questão presente nas seguintes provas
Homem, 52 anos, em investigação de perda ponderal, linfonodomegalias e tosse há trinta dias, realizou biópsia de linfonodo.
Na análise histopatológica, foi detectado o seguinte achado:

Qual é o diagnóstico mais provável?

Qual é o diagnóstico mais provável?
Provas
Questão presente nas seguintes provas
Mulher, 32 anos, em atual avaliação de anemia macrocítica, realizou o seguinte esfregaço periférico:

Qual é a principal alteração encontrada?
Qual é a principal alteração encontrada?
Provas
Questão presente nas seguintes provas
A classificação laboratorial das dislipidemias sofreu modificações, e os valores referenciais e os alvos terapêuticos foram
determinados de acordo com o risco cardiovascular individual e com o estado alimentar. Assinale a afirmativa correta em
relação à classificação das dislipidemias.
Provas
Questão presente nas seguintes provas
As informações a seguir contextualizam a questão.
Leia-as atentamente.
A manutenção do nível de hemoglobina glicada (A1C) em 7% é considerada uma das principais metas de controle glicêmico para a maioria dos indivíduos com diabetes, com o objetivo de reduzir risco de complicações.
Provas
Questão presente nas seguintes provas
As informações a seguir contextualizam a questão.
Leia-as atentamente.
A manutenção do nível de hemoglobina glicada (A1C) em 7% é considerada uma das principais metas de controle glicêmico para a maioria dos indivíduos com diabetes, com o objetivo de reduzir risco de complicações.
Provas
Questão presente nas seguintes provas
O estridor laríngeo em recém-nascidos e lactentes pode ser causado por diversas condições, incluindo laringomalácia,
paralisia unilateral ou bilateral de pregas vocais; estenose subglótica; e, hemangioma subglótico. Sobre tais condições,
assinale a afirmativa INCORRETA.
Provas
Questão presente nas seguintes provas
O exame físico otoneurológico e os testes vestibulares, como prova calórica, v-HIT (
Video Head Impulse Test
) e posturografia, são importantes ferramentas para avaliar a função do sistema vestibular. Sobre a fisiologia e a semiologia da
função vestibular, assinale a afirmativa correta.
Provas
Questão presente nas seguintes provas
Paciente, sexo feminino, 50 anos, procura atendimento devido à perda auditiva progressiva unilateral à direita há cerca
de 15 anos, predominante em frequências graves. Refere que foi submetida à cirurgia de estapedotomia; porém, não
houve qualquer melhora da audição. Além disso, relata episódios de tontura desencadeados por sons altos; sente-se
incomodada por escutar sons de seu corpo como do piscar de olhos ou deglutição.
Resultados dos exames:
- Audiometria: apresenta perda auditiva condutiva (gap aéreo-ósseo), predominante em frequências graves e hiperacusia por via óssea no ouvido direito. Audiometria normal no ouvido esquerdo.
- Potencial Evocado Miogênico Vestibular (VEMP): os resultados do VEMP revelam uma resposta aumentada (aumento da amplitude) e diminuição do limiar no ouvido direito quando estimulado.
- Reflexos estapedianos: presentes e normais em ambos os ouvidos.
Com base nos resultados dos exames, o diagnóstico mais provável para tal paciente é:
Resultados dos exames:
- Audiometria: apresenta perda auditiva condutiva (gap aéreo-ósseo), predominante em frequências graves e hiperacusia por via óssea no ouvido direito. Audiometria normal no ouvido esquerdo.
- Potencial Evocado Miogênico Vestibular (VEMP): os resultados do VEMP revelam uma resposta aumentada (aumento da amplitude) e diminuição do limiar no ouvido direito quando estimulado.
- Reflexos estapedianos: presentes e normais em ambos os ouvidos.
Com base nos resultados dos exames, o diagnóstico mais provável para tal paciente é:
Provas
Questão presente nas seguintes provas
Cadernos
Caderno Container